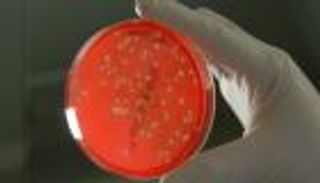

بالفيديو.. رئيس وزراء كندا يتحدى أوباما والملكة إليزابيث

رئيس وزراء الكندي جاستين ترودو، ينشر مقطع فيديو يتحدى فيه كلا من الرئيس الأمريكي باراك أوباما والملكة إليزابيث.. يتحداهما بماذا؟
نشر رئيس وزراء الكندي جاستين ترودو مقطع فيديو على حسابه الرسمي في مواقع التواصل الاجتماعية، تويتر وفيسبوك ويوتيوب، متحديا فيه كلا من الرئيس الأمريكي باراك أوباما وزوجته ميشيل، إضافة إلى ملكة بريطانيا إليزابيث وحفيدها الأمير هاري.
فكرة التحدي بنيت على انعقاد الدورة المقبلة من جولات Invictus والتي تستضيفها كندا في الثامن من مايو المقبل، وهي عبارة عن دورة ألعاب رياضية دولية للجنود وقدامى المحاربين الجرحى، التي أسّسها الأمير هاري بعد أن خدم في الجيش البريطاني.
وظهر ترودو في الفيديو إلى جانب الفريق الكندي المشارك في البطولة، قائلاً: "أنا فقط أريد أن أظهر لأصدقائنا في الولايات المتحدة والمملكة المتحدة كيف ستفوز كندا"، في إشارة إلى الفوز بالمسابقة، ثم اندفع إلى الأرض يقوم بحركات رياضة السواعد بكل ثقة وعزم.
وجاء الفيديو الذي نشره ترودو كرد على تغريدة لميشيل أوباما، قرينة الرئيس الأمريكي، والتي سألت فيها الأمير هاري إن كان جاهزا للمباريات من خلال فيديو طريف لها مع أوباما، موجهين خطابهما له، فما كان من الأمير هاري إلا أن رد بتغريدة وفيديو آخر بدا فيه جالساً إلى جانب جدّته ملكة إنجلترا، يطلعها على مجريات المباريات، وشاهدا خلاله فيديو الزوجين أوباما، فضحكا مستهزئين وواعدين بالفوز.
ومن الواضح أن ترودو لم يشأ البقاء خارج المنافسة، فرد على الطرفين معاً في هذا الفيديو الذي حصد حتى الآن نحو 4 ملايين مشاهدة على موقع يوتيوب، و130 ألف إعجاب على موقع فيسبوك، و5 آلاف إعادة تغريد على موقع تويتر.
رابط الفيديو: